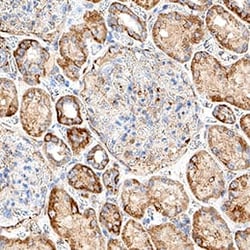
Human PIEZO1 Antibody, Novus Biologicals 100 &mu;g; Unconjugated:Anticorps,

missing translation for 'onlineSavingsMsg'
Learn More
Learn More
Human PIEZO1 Antibody, Novus Biologicals™
Mouse Monoclonal Antibody
Marque: R&D Systems MAB11557-100
Les retours ne sont pas autorisés pour ce produit.
Afficher la politique du retour.
Description
PIEZO1 Monoclonal antibody specifically detects PIEZO1 in Human samples. It is validated for Immunohistochemistry
Spécification
| PIEZO1 | |
| Monoclonal | |
| Unconjugated | |
| Lyophilized from a 0.2 μm filtered solution in PBS with Trehalose. | |
| FAM38A, KIAA0233, member A, membrane protein induced by beta-amyloid treatment, Mib, piezo-type mechanosensitive ion channel component 1, Protein FAM38A | |
| PIEZO1 containing synthetic peptide, Accession # Q92508 | |
| 100 μg | |
| Primary | |
| Reconstitute lyophilized material at 0.2 mg/mL in sterile PBS. For liquid material, refer to CoA for concentration. | |
| Use a manual defrost freezer and avoid repeated freeze-thaw cycles. 12 months from date of receipt, -20 to -70 °C as supplied. 1 month, 2 to 8 °C under sterile conditions after reconstitution. 6 months, -20 to -70 °C under sterile conditions after reconstitution. | |
| IgG2b |
| Immunohistochemistry | |
| 1081418 | |
| Immunohistochemistry 3-25 μg/mL | |
| Q92508 | |
| Mouse | |
| Protein A or G purified from hybridoma culture supernatant | |
| RUO | |
| 9780 | |
| Human | |
| Purified |
Correction du contenu d'un produit
Veuillez fournir vos retours sur le contenu du produit en remplissant le formulaire ci-dessous.
Nom du produit
Vous avez repéré une opportunité d'amélioration ?Partager une correction de contenu